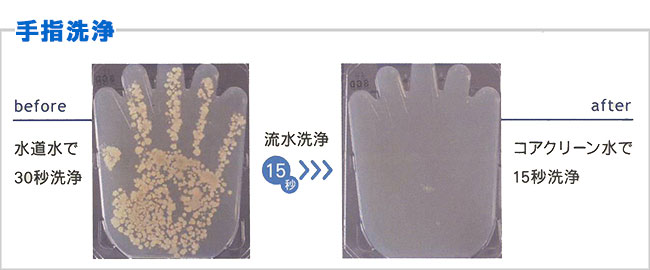
微酸性次亜塩素酸水生成装置「コア・クリーン」食中毒や感染予防対策に。

コアクリーン25 【KCM-2500】微酸性次亜塩素酸水生成装置 電解水】微酸性次亜塩素酸水生成装置「コア・クリーン25C」株式会社
(3419件)
Pontaパス特典
サンキュー配送
17400円(税込)
174ポイント(1%)
Pontaパス会員ならさらに+1%ポイント還元!
送料
(
)
3402
配送情報
お届け予定日:2026.04.23 23:35までにお届け
※一部地域・離島につきましては、表示のお届け予定日期間内にお届けできない場合があります。
ロットナンバー
18762238321
お買い物の前にチェック!

Pontaパス会員なら
ポイント+1%
ポイント+1%
商品説明






コア・クリーン25次亜塩素酸水生成器「コア・クリーン25」「食品添加物」として認められています!コア・クリーンシリーズで生成する微酸性次亜塩素酸水は、食品添加物に指定された「次亜塩素酸水」の成分規格を満たしています。高い殺菌・除菌効果と安全・安心・エコが特長の洗浄殺菌・除菌水・希釈不要ですぐに使えます。・小型・軽量でありながら、毎分2.5ℓの生成能力・非接触のハンドセンサーの採用で衛生面も安心・連続生成:最大200ℓコア・クリーン25(KCM-2500)製品仕様■型式:KCM-2500■寸法:270(W)×110(D)×303(H)mm■重量:3.6kg■電源:AC100V 50/60Hz■定格電流:1A(消費電力:60W)■作動水圧:0.1~0.75MPa■水温:5~35℃■生成水量:2.5ℓ/分■有効塩素濃度:20(±10)ppm■生成水pH:5.0~6.5■使用添加液:専用添加液■添加液タンク容量:500㎖(500㎖の添加液で洗浄除菌水を400ℓ生成)義父が喫茶店で使用していましたが、閉店の為、出品します。詳しい仕様はメーカーのHPを参照して下さい。動作や生成水の有効塩素濃度に問題がない事は試験紙にて確認済です。添加液1ℓも付属します。使用期間は2年弱で、使用頻度は高くありませんでした。45万円程で購入しています。お気軽にコメント下さい。宜しくお願いします。
| カテゴリー: | 生活家電・空調>>>生活家電>>>その他 |
|---|---|
| 商品の状態: | やや傷や汚れあり","目につく傷や汚れがある |
| 配送料の負担: | 送料込み(出品者負担) |
| 配送の方法: | 佐川急便/日本郵便 |
| 発送元の地域: | 栃木県 |
| 発送までの日数: | 1~2日で発送 |
レビュー
商品の評価:




 4.7点(3419件)
4.7点(3419件)
- ゆこゆこ6881
- コスパがいいです。純正品と比較しても裏側の型が違いだけで大満足です。
- ぽにょ3175
- ブラシが擦れて削れてしまったので、こちらで購入しました。ブラシの先がバシバシとタイヤに当たり、かなりうるさいですが、よく掻き取ってくれてるので我慢してます。ローラーも新しいので少しキュルキュル言いますが、とても働き者です。
- 楽天UFO
- 購入後、翌日に届けてもらえました。掃除するのに必需品なので楽天で買えるのはとても助かります。
- かず1138
- 注文番号:335769-20190927-00980704 特に問題無く使えました。安くて助かります。
- Haruriruriru
- 迅速な配送でよかったです。価格も手頃です。
- ayu926
- ヘルパーさん頼りの生活をしていますが掃除の時間拭き掃除までは時間が無いのでロボット拭き掃除機を!こまめにに掃除しても当分シートは大丈夫です。
- 37532383
- レビューを参考に購入しました。いい商品です。
- のっぽchan
- 消耗品でこの値段はありがたいです! 注文後も早く届いたのでたいへん満足です! 次も購入したいと思います。 注文番号:335769-20201123-00111712
- はち9097
- とても使いやすく、気に入っています。 シンプルで邪魔にならないデザインでいいです。
すべて見る
お店の情報
7,367
連絡・応対
4.3
配送スピード
4.3
梱包
4.3